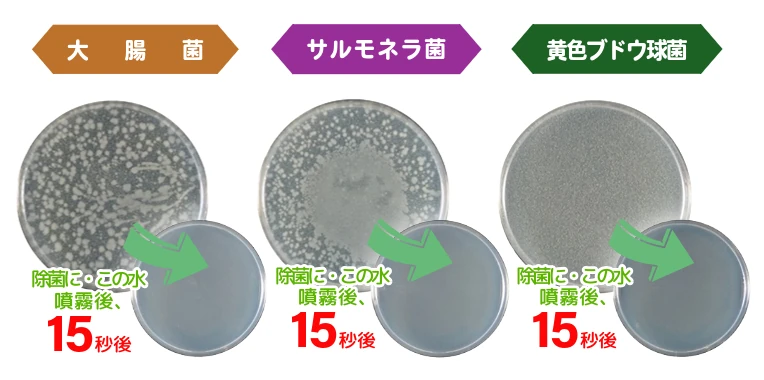

微酸性電解水「除菌に・この水」
使用方法
- 除菌したい所やニオイの気になる所に直接噴霧して下さい。噴霧後15秒で除菌できます。
- 拭き取りたい場合は噴霧後15秒以上してから拭き取って下さい。
使用上の注意
- 用途以外には使用しないで下さい。
- 他の液剤・薬品等と混ぜないで下さい。
- 高温になる所、直射日光の当たる場所を避け、密閉し常温または冷蔵庫で保管して下さい。
- 他の容器に移し替えないで下さい。
- 使用期限(商品ラベルに記載)以内にご使用下さい。
使用期限について
ご注文を受けてから製造し、できたてをお届けいたしますが、除菌成分の濃度は徐々に低下し、pHも徐々に中性に変化して、普通の水に戻っていくので、製造後7ヶ月の使用期限となります。
※使用期限は商品ラベルに印字しております。